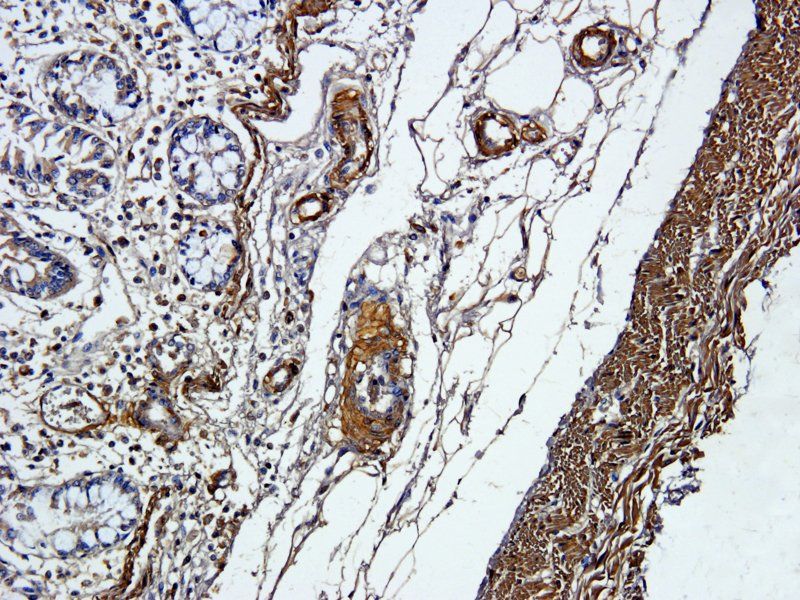
ACTA2 antibody
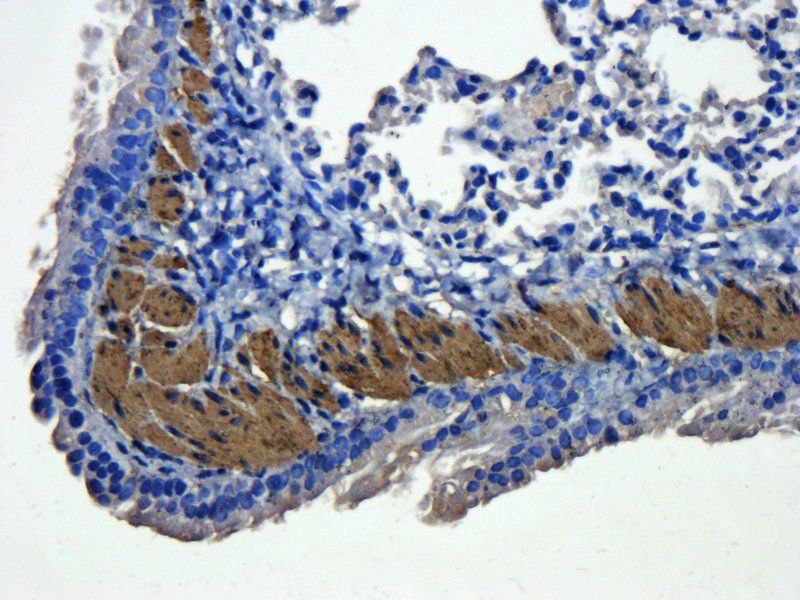
ACTA2 antibody
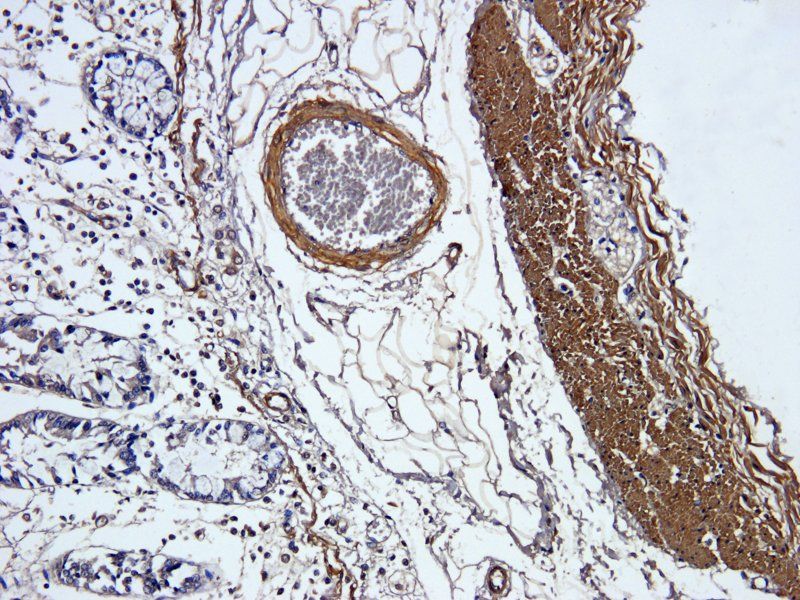
ACTA2 antibody
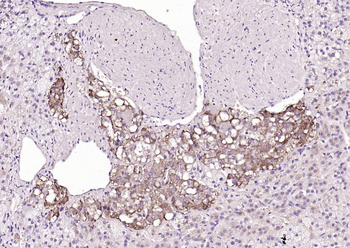
CHGA Rabbit Polyclonal Antibody

You have no items in your shopping cart.
All Products
- Goat Anti-Rabbit IgG H&L, Biotin conjugated [orb868233]
ELISA, FC, ICC, IF, IHC-Fr, IHC-P, WB
Rabbit
Goat
Polyclonal
Biotin
100 μl, 1 ml - Featured

ICC, IF, IHC-Fr, IHC-P, WB
Human, Mouse, Rat
Mouse, Rat
Rabbit
Recombinant
Unconjugated
100 μl, 25 μl, 50 μl - Featured

FC, ICC, IF, IHC-Fr, IHC-P, WB
Human, Mouse, Rat
Mouse, Rat
Rabbit
Recombinant
Unconjugated
25 μl, 100 μl, 50 μl - ACTA2 antibody [orb195993]Featured

ICC, IF, IHC-P, WB
Human, Mouse, Porcine, Rat
Rabbit
Polyclonal
Unconjugated
100 μg - EGFR isoform a variant antibody [orb308736]Featured

ELISA, ICC, IF, IHC-P, WB
Human, Mouse, Porcine, Rat
Rabbit
Polyclonal
Unconjugated
100 μg - VEGF antibody [orb191500]Featured

ELISA, ICC, IF, IHC-P, WB
Bovine, Canine, Gallus, Guinea pig, Human, Mouse, Porcine, Rat, Sheep
Rabbit
Polyclonal
Unconjugated
100 μg, 200 μg - TIMP1 antibody [orb195994]
ELISA, ICC, IF, IHC-P, WB
Bovine, Canine, Guinea pig, Human, Mouse, Porcine, Rat, Sheep
Rabbit
Polyclonal
Unconjugated
100 μg - SF3B3 Antibody [orb1402085]
ELISA, FC, ICC, IF, IHC, WB
Human, Mouse, Rat
Rabbit
Polyclonal
Unconjugated
100 μg - CHGA Rabbit Polyclonal Antibody [orb2563460]Featured

FC, IF, IHC-Fr, IHC-P, WB
Human, Mouse, Rat
Human, Rat
Rabbit
Polyclonal
Unconjugated
50 μl, 100 μl, 200 μl